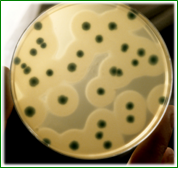
CHROMOCYTOGENES Agar Listeria monocytogenes: colonias verdes con halo, Rhamnosa positivas y Xylosa negativas
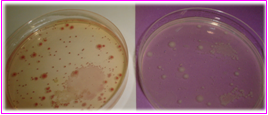
PCA-MILK-Cromogenic Agar En los tres medios las colonias rojas contrastan con el color del medio, las partículas, las burbujas y la membrana.
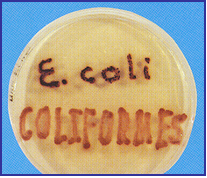
MUGPLUS Cfs.Agar E.coli: colonias azul-violetas, demás coliformes: colonias rosas
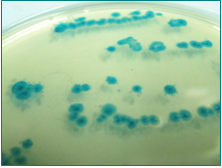
T.B.X. Agar E.coli: colonias verde-azuladas
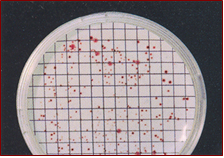
YEA-Cromogenic Nutrient Agar

MEDIOS CROMOGÉNICOS MICROKIT: CROMOKIT. DESDE QUE CREAMOS EL PRIMERO (1995), NO HEMOS PARADO, AHORA OFRECEMOS 30 AGARES Y 11 CALDOS EN 2023, Y SEGUIMOS INVESTIGANDO
CROMOKIT® Medios de cultivo cromogénicos

RAPIDTEST Broth
Diferentes tonos de viraje en función de la carga microbiana total y el tiempo de incubación

MCC Broth
Coliformes: Caldo azul turquesa. E.coli: Fluorescente bajo luz UVA de 366 nm e indol (anillo rojo) positivo

CHROMOSALM Agar
Salmonella: colonias verde-azuladas
falsos positivos de otros medios (Proteus, Citrobacter y demás enterobacterias): colonias negras o incoloras
CHROMOCYTOGENES Agar
Listeria monocytogenes: colonias verdes con halo, Rhamnosa positivas y Xylosa negativas
PCA-MILK-Cromogenic Agar
En los tres medios las colonias rojas contrastan con el color del medio, las partículas, las burbujas y la membrana.
Medios Cromogénicos MICROKIT® – Innovación y Precisión en Microbiología Desde 1991
En Laboratorios MICROKIT® somos pioneros en el diseño y fabricación de una de las gamas más amplias de medios cromogénicos del mercado mundial.
Desde los años 90, desarrollamos agares y caldos cromogénicos para el análisis microbiológico de alimentos, aguas, cosméticos, superficies y aire, fabricados íntegramente en España con la más alta calidad.
Ofrecemos nuestros productos tanto en versión deshidratada como en formato preparado, disponibles en múltiples presentaciones: tubos, frascos, ampollas MF, placas herméticas PLAQUIS® y kits Presencia/Ausencia (P/A).
Ventajas de los Medios Cromogénicos MICROKIT®
AGARES CROMOGÉNICOS
- Permiten una identificación visual clara y específica, ya que solo las colonias (y no el medio) se colorean con el cromógeno.
- Diferencian fácilmente colonias solapadas de microorganismos distintos.
- Utilizan sustratos enzimáticos, mucho más específicos que los colorantes bioquímicos tradicionales.
CALDOS CROMOGÉNICOS
- Ofrecen un rápido despistaje de muestras negativas con una sensibilidad superior a los medios clásicos.
- Detectan la presencia o ausencia del microorganismo diana en menos tiempo y con mayor fiabilidad.
Evolución de Nuestros Medios Cromogénicos
1991 – RAPIDTEST Broth
Nuestro primer caldo cromogénico, diseñado para la detección rápida de la carga microbiana aerobia mediante un viraje de color a rojo.
Ideal para la industria alimentaria y química, permite determinar el bioburden en solo 4 a 24 horas.
- 10⁶ ufc/g → viraje en 3–4 h
- 10⁵ ufc/g → viraje en 7–8 h
- 10⁴ ufc/g → viraje en 10–12 h
- 10³ ufc/g → viraje en 13–18 h
Si el producto no debe superar 10⁴ ufc/g, bastan 12 horas de incubación para confirmar su validez.
Incluso es posible detectar de forma precoz el viraje inicial (color rosado) antes del resultado final, dependiendo de la matriz.
1999 – MUGPLUS Cfs.Agar
Primer agar cromogénico MICROKIT®.
- E. coli: colonias azules (X-Glu)
- Coliformes: colonias rosas (Salmon-Gal)
Resultados en 18–24 horas en una sola placa, tanto por filtración de membrana como por siembra directa.
Comparado con medios como Endo, M-FC, COLITAG o COLI-ID, MUGPLUS ofrece mayor sensibilidad, especificidad y precisión.
Cumple la Norma ISO 9308-1 y presenta correlación 100% con el medio validado de otra marca pionera.
2001 – MCC Broth
Caldo Lauryl-Sulfato con MUG y X-Gal que permite la detección simultánea de Coliformes y E. coli en 18–24 horas en un mismo tubo.
- E. coli: fluorescencia azul bajo luz UVA (366 nm) + indol positivo con reactivo de Kovacs.
- Coliformes: viraje a azul turquesa.
No requiere campanas Durham ni agua de triptona posterior.
Ideal para recuentos NMP o detección P/A en aguas y bebidas.
Validado por más de 15 años de estudios intercomparativos.
2002 – CHROMOSALM ABC Agar
El medio más específico y sensible para la detección de Salmonella.
- Salmonella: colonias verdes (X-α-Gal).
- Otras Enterobacterias: colonias incoloras o negras (CHE-Gal).
Evita interferencias de Proteus y Citrobacter, comunes en otros medios incluso cromogénicos.
Elimina la necesidad de kits de confirmación adicionales.
Cumple la Norma ISO 6579 y ha demostrado máxima eficiencia en estudios intercolaborativos.
2003 – T.B.X. Agar
Agar para la detección de E. coli con colonias verde-azuladas.
Basado en el T.B.A. (ISO 9308-1), al que se ha añadido el cromógeno X-Glu.
Cumple las Normas ISO/TC 34/SC9 e ISO/TS 16649-2.
2004 – CHROMOCYTOGENES Agar
Diseñado según la Norma ISO 11290-2004 para la detección de Listeria monocytogenes.
Fuimos los primeros en ofrecerlo en formato deshidratado, ampliando su vida útil frente a las placas preparadas.
Demuestra correlación 100% con los medios Ottaviani & Agosti (ALOA).
2006 – PCA-Cromogenic Agar, PCA-MILK-Cromogenic Agar, YEA-Cromogenic Nutrient Agar y TSA Maxim Agar
Cuatro medios diseñados para el recuento total de aerobios en diferentes matrices:
- PCA-Cromogenic: alimentos (ISO 4833, AOAC, APHA).
- PCA-MILK-Cromogenic: lácteos (FIL).
- YEA-Cromogenic: aguas (ISO 6222).
- TSA MAXIM Agar: cosméticos con visualización más rápida y evidente
Las colonias crecen rojas sobre fondo crema, aumentando la visibilidad y precisión del recuento (>110% de sensibilidad frente a medios clásicos).
El analista deja de forzar la vista y distingue fácilmente colonias de partículas, burbujas o la membrana filtrante.
Innovación Continua: Nuestro Departamento de I+D+i
En Laboratorios MICROKIT® seguimos desarrollando nuevos medios cromogénicos que optimizan la eficiencia y fiabilidad de los análisis.
Nuestros últimos lanzamientos incluyen medios específicos para la detección de:
- Candida albicans
- Burkholderia cepacia
- Pseudomonas aeruginosa
- Microorganismos UTI
- Patógenos emergentes en cosméticos
- Esporulados termoresistentes HRS
- Staphylococcus aureus
- Clostridium perfringens
- Campylobacter spp.
- Enterococos fecales
- E.coli O157
- Lactobacilos
- Levaduras y mohos
- Bacillus cereus
- Vibrio parahaemolyticus
- Enterobacter (Cronobacter) sakazakii
Nuestra innovación es suya: desarrollamos soluciones prácticas, seguras y eficientes para los laboratorios del presente y del futuro.
Todas las publicaciones y estudios que avalan los resultados mencionados están disponibles en nuestra web oficial:
http://www.microkit.es
Desde que se editó esta noticia hemos diseñado numerosos medios cromogénicos nuevos. El folleto más actualizado es este, pero nuestro I+D es mucho más rápido que nuestras entradas al blog (y por supuesto muchísimo más rápida que la Normalización de métodos):
https://www.microkit.es/pdf/CROMOKIT-2021.pdf
Prepárese para más de una sorpresa informativa cuando vea nuestro video sobre los medios Cromogénicos: https://www.youtube.com/watch?v=-JVPVWxY8ZE&t=271s
Si desea más información y precios actualizados sobre nuestros MEDIOS póngase en contacto con nosotros a través de nuestro correo electrónico microkit@microkit.es o por teléfono en el nº 91-897 46 16
https://www.microkit.es/monograficos/17-Medios-cromog–nicos-monograf–a.pdf

necesito información si ustedes tienen algún distribuidor en MEXICO .
ME URGE COTIZAR UN PRODUCTO DE SU MARCA
Hola, puedes consultarlo en microkit@microkit.es